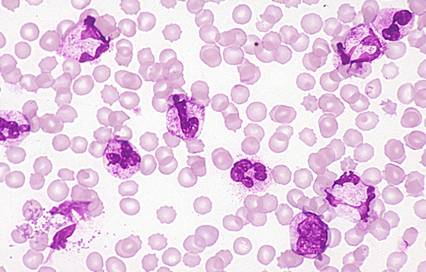

|    |

全登録症例数:225
全登録画像数:1755
全登録画像数:1755


■詳細データ
| 診断材料 |
末梢血 |
| 染色 |
メイ・ギムザ |
| 光顕的所見 |
末梢血では白血球増加(50,000/μl)にて好中球が優位であった。それらは変性気味の形態が多くみられた。
【MG.×400】 |
本サイトは、厚生労働省がん研究助成金総合研究事業および、厚生労働省第3次対がん総合戦略研究事業にて構築され、2014年3月にその事業を終了しております。現在サイトに掲載されている内容は当時の登録状況のまま公開しているため、必ずしも最新の医療に沿う内容ではない場合がございます。ご注意ください。
ご不明点がありましたら九州がんセンターまでお問い合わせください。

全登録症例数:225
全登録画像数:1755 |

■詳細データ
|
| ||||||